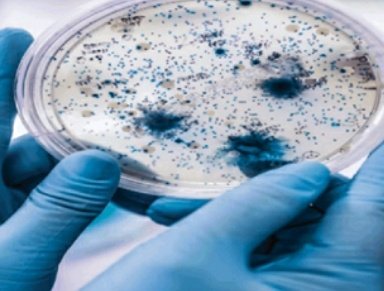

الميكروبات مفيدة لصحتك .. هذا ما يقوله العلم
كريتر نيوز/صحة
يؤكد الخبراء على أن وجود البكتيريا والفيروسات والطفيليات في أمعائك، ضرورية جداً لصحتك.
وقالت الباحثة إليزابيث كوروين، إن الميكروبيوم، وهو مجموعة الميكروبات التي تعيش داخل أمعائك، يعتبر واحد من مسببات الصحة الجيدة.
وأوضحت أنه يؤثر على جهاز المناعة ويساعد على امتصاص فيتامينات مهمة في أمعائنا.
ولفتت كوروين إلى أن أمعاء الجميع قابلة للتسريب إلى حد ما، لكن أحشاء بعض الناس أكثر قابلية للتسريب من غيرها.
وأضافت أنه في حال تسربت الكائنات الحية الدقيقة الصحية والمفيدة من أمعائك، فلا بأس بذلك، ولكن إذا تم بتسريب المزيد منها، فسوف تنشط الخلايا المناعية، مما قد يتسبب في حدوث التهاب.
من جانبها، قالت الأستاذة في قسم العدوى والمناعة وطب الجهاز التنفسي بجامعة مانشستر في المملكة المتحدة، شينا كروكشانك: إن هذه الكائنات الحية تقضي على مسببات الأمراض السيئة، وتساعد بعض الأدوية على العمل بشكل أفضل.
وأضافت: إن العناية بالميكروبيوم الخاصة بك يمكن أن يساعدك في العديد من الحالات، بما في ذلك الحساسية والربو وأمراض المناعة الذاتية.
وأكملت كروكشانك قائلة: إنها قلقة بشأن الميكروبيومات للأشخاص الذين يحدون من طعامهم، إما بسبب اتباع نظام غذائي مقيد أو لأنهم يعتمدون على أطعمة غنية بالدهون.
وأضافت: “إذا كان لديك نظام غذائي متنوع يحتوي على الكثير من الفواكه والخضروات، فهذا يمنحك المزيد في طريقك نحو الحصول على صحة جيدة”.